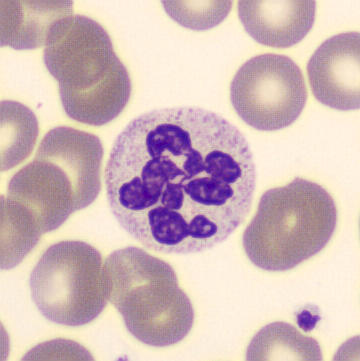
Polynucléaires neutrophiles élevés : causes et symptômes

Le régime hôtesse de l’air, ou Régime Natman, se présente comme une solution rapide pour perdre des poids en seulement quatre jours. Inspiré par les habitudes alimentaires des hôtesses de l’air qui doivent rester en forme entre deux vols, ce régime impose une alimentation hypocalorique et hyperprotéinée, consistant principalement en viandes maigres, poissons, légumes verts et fruits peu sucrés, tout en excluant les sucres, féculents et matières grasses. L’idée est de permettre au corps de puiser dans ses réserves, sans avoir recours à une activité sportive.
Les avis sont partagés sur cette méthode. Si elle peut engendrer une perte de poids rapide, de nombreux experts mettent en garde contre les carences nutritionnelles potentielles et les risques d’effet rebond. De plus, l’engagement strict requis peut s’avérer difficile et conduire à des compulsions alimentaires après la diète. Une fois les quatre jours écoulés, une phase de transition est fortement conseillée pour éviter de reprendre rapidement les kilos perdus. En somme, cette méthode peut répondre à un besoin ponctuel, mais elle n’est pas une solution à long terme pour une alimentation équilibrée.
Découvrez le régime hôtesse de l’air : une méthode rapide pour perdre du poids ! 🌟
Chaque printemps, beaucoup d’entre nous ressentent l’envie de perdre quelques kilos, surtout avec l’arrivée des beaux jours. Si vous cherchez une méthode efficace et rapide, le régime Natman, aussi appelé régime hôtesse de l’air, pourrait être une option à considérer. 🌼
Un régime express : les grands principes
Ce régime, qui dure 4 jours, est basé sur un principe hypocalorique et hyperprotéiné. Cela signifie que vous allez surtout consommer des aliments très faibles en calories, mais riches en protéines, et limiter drastiquement vos choix alimentaires. 🥗
Voici ce que vous pourrez manger pendant ces 4 jours :
- Viande maigre (poulet, dinde, bœuf sans gras)
- Poisson blanc (cabillaud, colin, merlan)
- Œufs (cuits sans graisse)
- Légumes verts (épinards, haricots verts, courgettes, laitue)
- Fruits pauvres en sucre (principalement pamplemousse)
- Thé ou café sans sucre
À éviter absolument :
- Sucre (sous toutes ses formes)
- Féculents (pâtes, pain, riz, pommes de terre)
- Produits laitiers (sauf yaourt 0 % exceptionnellement)
- Matières grasses et sauces
- Alcool, sodas, jus de fruits
Un exemple de menu pour la première journée
- Petit-déjeuner : 1 pamplemousse + café noir sans sucre
- Déjeuner : blanc de poulet grillé + haricots verts vapeur
- Dîner : filet de poisson + épinards cuits nature
Les avantages et inconvénients du régime Natman
Le régime Natman a ses partisans grâce à sa promesse de perdre jusqu’à 4 kilos en seulement 4 jours. Cependant, il est essentiel de rester vigilant. 🎯
Ce que dit la science 🔍
Des experts mettent en garde que cette méthode, bien que rapide, ne repose pas sur des bases d’éducation alimentaire durables. En effet, un régime aussi restrictif peut entraîner des carences nutritionnelles. Le risque est encore plus élevé si vous avez des antécédents médicaux ou des troubles alimentaires. 🚫
Éviter l’effet yo-yo
Après avoir suivi ce régime, beaucoup reprennent-weight rapidement en raison d’une phase de transition mal gérée. Voici quelques conseils pour éviter cela :
- Réintroduisez progressivement les féculents, les fruits sucrés et les bonnes matières grasses.
- Misez sur une alimentation équilibrée durable.
- Intégrez une activité physique modérée, comme la marche rapide ou le yoga.
Un régime à envisager ? 🤔
Le régime Natman est envisageable pour vous si :
- Vous souhaitez atteindre un objectif ponctuel.
- Vous êtes en bonne santé et capable de suivre un régime strict.
En revanche, il n’est pas recommandé si :
- Vous recherchez une perte de poids durable.
- Vous avez déjà connu des troubles alimentaires.
- Vous êtes en état de fatigue permanente ou de carences.
Pour plus d’astuces santé, consultez cet article sur remplacer le pain pour maigrir. Découvrez également comment personnaliser vos repas avec les crêpes Herbalife.
Enfin, gardez à l’esprit que le meilleur régime est souvent celui qui prône un équilibre sur le long terme, sans frustrations ni privations excessives. 🌈

Régime hôtesse de l’air : un témoignage sur le programme de 4 jours
Le régime hôtesse de l’air, connu sous le nom de Natman, a suscité des attentes considérables en termes de perte de poids rapide. Beaucoup y voient une opportunité de se sentir mieux dans leur peau, surtout avant un événement important. Ce programme promet une réduction de poids pouvant aller jusqu’à 4 kilos en seulement 4 jours, une perspective séduisante pour ceux qui ont besoin d’une solution express.
Cependant, il est essentiel de reconnaître que ce régime est très restrictif. Les menus sont rigoureusement planifiés, se concentrant essentiellement sur des protéines maigres, des légumes et des fruits à faible teneur en sucre, tout en excluant bon nombre d’aliments courants. La stimulation de la satiété par ces choix alimentaires peut fonctionner à court terme ; pourtant, cette méthode laisse peu de place pour le plaisir de manger et peut même mener à des frustrations.
Les opinions des experts sur ce régime sont partagées. Bien qu’il permette une perte rapide de poids, certains nutritionnistes mettent en garde contre les carences nutritionnelles qu’il pourrait engendrer si l’on ne l’accompagne pas d’une réintroduction progressive et équilibrée des aliments après cette période. L’effet yoyo, avec une reprise rapide des kilos perdus, est également un facteur préoccupant pour beaucoup.
Ainsi, bien que le régime hôtesse de l’air puisse se révéler efficace pour un objectif à court terme, il peut aussi s’avérer inadapté pour ceux qui recherchent des changements durables et sains. En matière de santé, la modération et l’équilibre restent d’indispensables alliés pour atteindre des résultats positifs et durables.